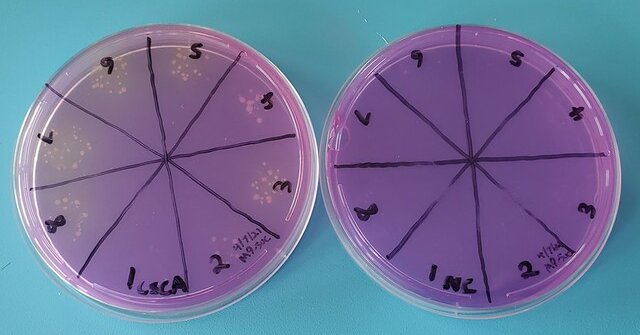

Kai Zhou
@LukerChow
Followers
167
Following
4K
Media
5
Statuses
359
PhD candidate in crop genetics @ SWU, Chongqing | All about flowering time 🌸 | Fan of pandas (especially 🐼Hua & Waka 🐼) & cats 🐱
Chongqing,China
Joined August 2013
Devastatingly disappointing display of self-serving myopia. Villains convinced they are heroes is one of the most terrifying mental prisons one can ever exist in. The damage stunts like this cause to the optics of their movement is incalculable.
10
6
110
Hi Friends, I'm excited to announce that I set up a crowdfunding campaign for my sugar selection system for antibiotic-free cloning! Finally formalizing this project; it's been a dream for too long now. Every penny counts; please RT! 💚🍬🦠 https://t.co/MOKKm2cTp7
experiment.com
The access to educational resources for hands on biotech in the classroom, globally, is heavily constrained by the exotic and/or regulated reagents used in routine bioengineering protocols. The need...
11
214
473
Circumnutation is a common plant behavior in which plants rotate around a central axis, allowing exploration of the surrounding 3D space. This movement is the achievement of coordinated cell growth and turgor pressure changes, and was first analyzed in detail by Charles Darwin.
5
149
688
Questions to deal with: Does florigen degrade? How does it degraded?
@ATinyGreenCell Trivia question: how long was it between the discovery of Florigen as a phenomenon and its elucidation as a specific molecule?
1
0
0
I am so shocked that Prof. Dabing Zhang from Shanghai Jiaotong University passed away today because of a serious traffic accident yesterday middle night. He is a great plant scientist. Rest in peace, Prof. Zhang!
16
13
71
🌈All the light the plants can see🌈 This nice illustration was made by Varvara Dikaya, read the entire post at https://t.co/FEtXeKURFI
#Scicomm #Plantscience #Plantsci #photosynthesis
1
6
15
Learn more about the methods our authors used to ID our #100PlantQuestions in this thread by @emilyxarmstrong!
What are the biggest issues facing plants globally? How do we work as a team to tackle them? Delighted to share my 1st author paper, '100 questions facing plant science: an international perspective' How did we ID our Qs? What did we find? https://t.co/jEvuxvZa2R 1/n
0
22
70
Rice protoplast with over expression GFP broken just like a comet.
1
1
2
Oryza sativa PECTIN DEFECTIVE TAPETUM1 affects anther development through a pectin-mediated signaling pathway in rice (Wuzhong Yin, Hongxia Yang, Yantong Wang, Ping Feng, Yao Deng, Lisha Zhang, Guanghua He, Nan Wang) #PlantSci
https://t.co/BBwcnUVvZK
2
15
34
SALES! Like & retweet and in 24 hours I'll send 5 of you (randomly) a bundle of codes for these 4 apps! 🤩 Home Agenda Calendar Widget: https://t.co/y37rylB3le FK Kernel Manager: https://t.co/FCzRGMzifs Naptime: https://t.co/zDYKUwmvAW Servicely: https://t.co/1wg0QbJObx
35
175
257
I scored 3072 points at 2048, a game where you join numbers to score high! #2048game #2048ai
https://t.co/rLjXhMd4cf 来自 @gabrielecirulli
0
0
0
故事的最后,恺之依然凭借关键时刻的掐指一算,携其友一同登上了开往南极的豪华游轮。——「知乎世界杯竞猜大奖赛」 http://t.co/XyVlDITtWD
0
0
2